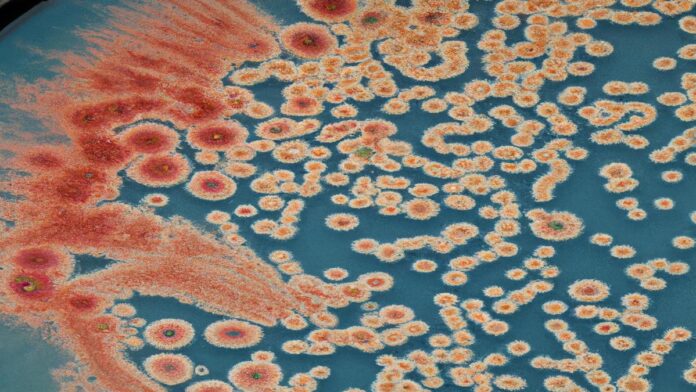

Las bacterias son organismos unicelulares microscópicos que pertenecen al dominio de los procariotas – organismos cuyas células no contienen un núcleo definido. Se ubicaron por primera vez en 1674 por el científico holandés Antonie van Leeuwenhoek al observar placas de sarro dental. Desde entonces, hemos aprendido que las bacterias se encuentran en prácticamente todas las formas de hábitat, desde el suelo y los cuerpos de agua hasta la piel y el tracto digestivo de los animales.
La mayoría de las bacterias miden entre 0,5 y 5 micrómetros de longitud – mucho más pequeñas que una célula humana promedio, que mide alrededor de 30 micrómetros. Las bacterias pueden tener varias formas, incluyendo esferas (cocos), varillas (bacilos), y espiraleadas (espirilos o espiroquetas).
Por otro lado, algunas presentan formas más complejas, como las estrellas y los cuadrados.
Las bacterias también varían enormemente en su composición genética.
Cada bacteria tiene un genoma de ADN circular que contiene su información genética, y muchas también tienen plásmidos, pequeños anillos de ADN que pueden ser transferidos de una bacteria a otra.
Este intercambio de plásmidos permite que las bacterias adquieran rápidamente nuevas habilidades o características, como la resistencia a los antibióticos.
En general, las bacterias son vitales para nuestra existencia y para la salud del planeta.
Pueden descomponer sustancias que otros organismos no pueden, jugando un papel crucial en la descomposición y el reciclaje de la materia orgánica. En el tracto gastrointestinal, las bacterias ayudan a descomponer los alimentos, producir vitaminas, estimular el sistema inmunológico y prevenir el crecimiento de bacterias nocivas. Este conjunto de bacterias se conoce como microbiota y se está comprendiendo cada vez más su papel crucial en la salud humana. Estas bacterias patógenas pueden producir toxinas, invadir tejidos y células, o simplemente desplazar a las bacterias benignas. Las bacterias también pueden ser la causa de enfermedades graves como la tuberculosis, la sífilis, la salmonelosis o la neumonía. A medida que utilizamos antibióticos para tratar infecciones bacterianas, las bacterias pueden desarrollar resistencia a estos fármacos a través de mutaciones genéticas o la adquisición de genes de resistencia. Este proceso de evolución rápida ha llevado a la aparición de `superbacterias` resistentes a múltiples antibióticos, lo que supone un importante desafío para la atención de salud. En resumen, las bacterias son unos de los organismos más ubicuos, diversos y adaptativos del planeta. Aunque algunas pueden causar enfermedades, muchas juegan roles vitales en los ecosistemas y en nuestra propia salud. La investigación continua y la vigilancia son necesarias para entender y mitigar los riesgos asociados con las bacterias patógenas, y para explotar al máximo los beneficios de nuestras relaciones simbióticas con las bacterias beneficiosas.
.